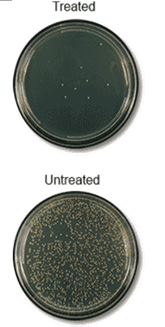

1.更薄的纤维直径(纳米纤维vs传统微纤维)意味著有更大的用来捕获微粒的表面面积。
2.无可比拟的捕获PM2.5(直径小于2.5微米的颗粒物)的效率
3.美国环境保护局:对人类 “健康的危害可能性最大”
捕获更大范围和更大量的微粒意味著呼吸的空气更干净且更健康。

纳米纤维捕获的微粒
二.压力损失
1.在维持过滤效率的同时減少压力损失(或提高过滤效率的同時保持压力损失)
2.降低压力损失等于节省能量(成本)!

三.负载能力
1.承载更多微粒,延长生命周期
2.通过減少维护费用节省成本




一.ANSI/ASHRAE 标准 52.2-2007 (“ASHRAE 52.2”) 是由 ASHRAE, 美国热力采暖, 制冷与空調工程师学会制定。ASHRAE 52.2 由过滤器捕捉颗粒性能(即,去除空氣中的顆粒)来测量空气器的过滤效率,颗粒的大小范围分为十二等级,从0.3μ 到 10μ。大多数空气过滤器测试条件为空气流速 492 fpm (英尺/分钟) 。
二.测试目的是确定过滤器的最低效率,又称MERV值。 MERV值为确定过滤器去除某大小颗粒性能提供了准则,测量是以空气过滤器的最低效率为基础(大多数情況下是在过滤器初装后进行)。为了测定MERV 评级,各种大小的固体颗粒從测试的过滤器的上流(过滤器的前面)和下游(过滤器的后面)导入测试系统內。十二级范围的颗粒数目成倍增長。
三.ASHRAE 52.2 测试的最终结果将包括有关过滤器的过滤效率,压力下降和粉尘保持容量的信息。


ISO 20743:2007 是由国际标准化组织制定的。该测试提供了量化的测试方法以确定防菌成品的防菌性能,包括无纺布在內。该标准适用于所有的纺织产品,包括布料、填塞物、线和衣服材料,家装材料以及杂货商品(包括空气过滤器)。按用途有三种测试方法可选。对于空气过滤器來说,适当的方式是吸收法,直接向样本上施加测试用的细菌悬液。
把已知数量的细菌分別放在已处理和未处理的样本上。细菌在样板本上停留24小时,以保证细菌的生长时间。24小时之后,把样本放在溶液內摇动,让样本上的所有细菌脱离样本。然后测试这个液体,查看细菌数最高的样本。
ISO 9001:2008, 质量管理体系
一.ISO 9001:2008 标准包含大量要求,实际上能影响任何公司的所有运营方面。该标准包括各种主题:质量管理体系,管理責任,资源管理,产品实现,测量,分析和改善。
二.ISO 9001 概括了执行标准中质量管理体系的必要步骤。强调了质量的上层管理责任和 ISO 9001质量管理体系,包括了各种必須保留的管理方式。该标准明确了公司要求,要求明确並及时提供实行並改进ISO 9001 质量管理系统的流程所需的资源(例如,设备,设施等),以达到客户滿意。此外,对于工作环境也有要求。从产品的角度來讲,重点是在于完成产品所需流程和次流程的顺序,包括关于产品设计、生产、测试、处理、运输等方面。最后,ISO 9001 提供了衡量和监督要求。如果程序偏离正轨,公司能立即确认这种情況並能持续改进。通过衡量和监管,公司能按照实际情況管理,而不是通过猜测进行管理。
三.希望得到 ISO 9001 认证的公司必須通过严格的审批程序,包括对于现场、功能、产品、服务和流程的广泛采样。这些认证程序必須通过受认证的独立的第三方进行,而且每三年更新一次。
